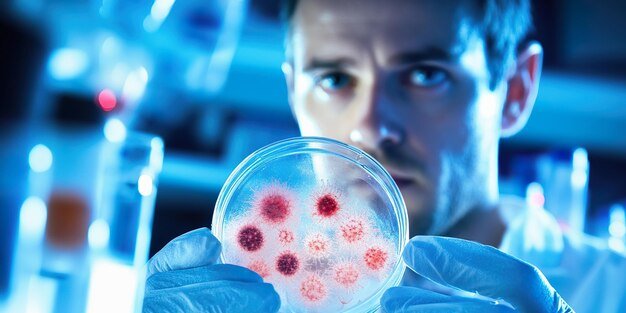

Immunohistochemistry
Immunohistochemistry (IHC) is an advanced diagnostic technique used to identify specific proteins and markers within tissue samples, helping in the accurate diagnosis and classification of various diseases, especially cancers. It plays a crucial role in detecting tumor types, determining disease progression, and supporting targeted treatment decisions. Our laboratory performs immunohistochemistry testing using advanced staining methods and modern diagnostic technology to deliver precise and reliable results. Each sample is carefully analyzed to provide detailed insights that assist clinicians in diagnosis, prognosis evaluation, and personalized therapy planning. With expert interpretation, strict quality standards, and advanced laboratory protocols, we are committed to providing accurate, timely, and dependable IHC reports.